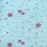
Самоклеюча 3D панель 700х770х4мм Блакитні кульбаби (322) SW-00001362

Панелі мікси
Декоративна 3D панель самоклейка 700х770х5мм Зірки (біла цегла) (021) SW-00000086
Декоративна 3D панель самоклейка під білу цеглу Зірки 700х770х5мм (021) Декоративні 3D панелі на самоклеючій основі. Тепер можна легко зробити ремонт за 1 день! При цьому не потрібно шукати підрядників для ремонту, немає пилу та будівельного сміття в будинку. Матеріал - спінений поліпропілен. Термін служби становить понад 20 років. Переваги панелей..
Декоративна 3D панель самоклейка 700х770х5мм Кульбабка (світло-рожевий цегла) (022) SW-00000023
Декоративна 3D панель самоклейка під світло-рожевий цегла Кульбабка 700х770х5мм (022) Декоративні 3D панелі на самоклеючій основі. Тепер можна легко зробити ремонт за 1 день! При цьому не потрібно шукати підрядників для ремонту, немає пилу та будівельного сміття в будинку. Матеріал - спінений поліпропілен. Термін служби становить понад 20 років. Пе..
Декоративна 3D панель самоклейка 700х770х6мм Помаранчевий (цегла графіті) (025) SW-00000081
Декоративна 3D панель самоклейка під помаранчеву цеглу графіті 700х770х6мм (025) Декоративні 3D панелі на самоклеючій основі. Тепер можна легко зробити ремонт за 1 день! При цьому не потрібно шукати підрядників для ремонту, немає пилу та будівельного сміття в будинку. Матеріал - спінений поліпропілен. Термін служби становить понад 20 років. Переваг..
Панель стінова 3D 700х700х4мм Дерева SW-00001987
3D панелі самоклеючі – декоративне покриття для стін, виконане з легкого та міцного матеріалу – пористого поліпропілену (ППП). Основна особливість – рельєфний малюнок у вигляді цегли у широкому різноманітті кольорів та наявність клейового шару, що дозволяє встановити панелі без необхідності застосування додаткових матеріалів. Панелі складаються з ..
Панель стінова 3D 700х700х4мм Сіро-зелені стільники мармур SW-00002006
3D панелі самоклеючі – декоративне покриття для стін, виконане з легкого та міцного матеріалу – пористого поліпропілену (ППП). Основна особливість – рельєфний малюнок у вигляді цегли у широкому різноманітті кольорів та наявність клейового шару, що дозволяє встановити панелі без необхідності застосування додаткових матеріалів. Панелі складаються з ..
Самоклеюча 3D панель 700х770х4мм Блакитні кульбаби (322) SW-00001362
Самоклеюча 3D панель блакитні кульбаби 700х770х4мм (322) Декоративні 3D панелі на самоклеючій основі тепер можна легко зробити ремонт за 1 день! При цьому не потрібно шукати підрядників для ремонту, немає пилу та будівельного сміття в будинку. Матеріал - спінений поліпропілен. Термін служби становить понад 20 років. Переваги панелей: Легкий монтаж..